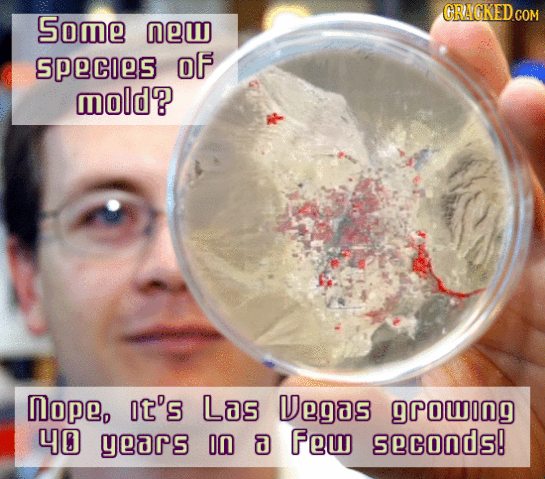
10 Sped-Up GIFs That Turn Normal Stuff Horrifyingly Awesome

10 Sped-Up GIFs That Turn Normal Stuff Horrifyingly Awesome
Suddenly sloths seem a little dangerous.
Fast-forwarding is great for a lot of things: skipping commercials, speeding through sex scenes when you're watching a movie with your parents, and ... OK, well fast-forwarding is great.
And now you can add a third thing to that list: Speeding up things that are slow or take a long time to happen. In fact, it makes watching those things pretty awesome.